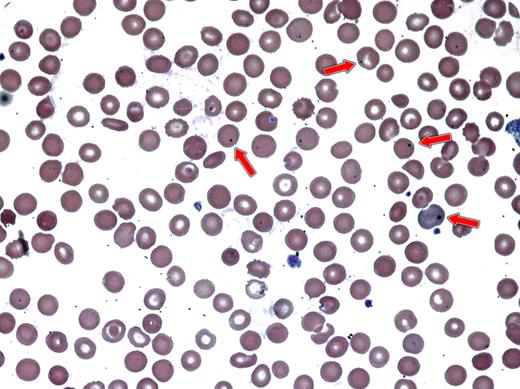
A 43-year-old man with history of relapsed diffuse large B-cell lymphoma was admitted for fever and cough. He had a history of prior autologous peripheral blood stem cell transplantation (PBSCT) 10 years earlier with subsequent disease progression. An allogeneic PBSCT from a HLA-matched unrelated donor was performed. His disease was in remission when he developed extensive chronic graft-versus-host disease (cGVHD) of skin and mouth. CT chest scan showed patchy consolidations. His peripheral blood showed Howell-Jolly bodies (red arrows). Subsequently, the patient died of pneumonia and progressive renal failure. / Chronic GVHD, which is associated with severe immune dysfunction and increased frequency of infections, may show numerous Howell-Jolly bodies. Normally, Howell-Jolly bodies are remnants of the erythroblast nucleus that are removed by the spleen. In patients with cGVHD, their appearance is associated with functional asplenia (Kalhs et al. Ann Intern Med. 1988;109:461-464).

A 43-year-old man with history of relapsed diffuse large B-cell lymphoma was admitted for fever and cough. He had a history of prior autologous peripheral blood stem cell transplantation (PBSCT) 10 years earlier with subsequent disease progression. An allogeneic PBSCT from a HLA-matched unrelated donor was performed. His disease was in remission when he developed extensive chronic graft-versus-host disease (cGVHD) of skin and mouth. CT chest scan showed patchy consolidations. His peripheral blood showed Howell-Jolly bodies (red arrows). Subsequently, the patient died of pneumonia and progressive renal failure.
Chronic GVHD, which is associated with severe immune dysfunction and increased frequency of infections, may show numerous Howell-Jolly bodies. Normally, Howell-Jolly bodies are remnants of the erythroblast nucleus that are removed by the spleen. In patients with cGVHD, their appearance is associated with functional asplenia (Kalhs et al. Ann Intern Med. 1988;109:461-464).
A 43-year-old man with history of relapsed diffuse large B-cell lymphoma was admitted for fever and cough. He had a history of prior autologous peripheral blood stem cell transplantation (PBSCT) 10 years earlier with subsequent disease progression. An allogeneic PBSCT from a HLA-matched unrelated donor was performed. His disease was in remission when he developed extensive chronic graft-versus-host disease (cGVHD) of skin and mouth. CT chest scan showed patchy consolidations. His peripheral blood showed Howell-Jolly bodies (red arrows). Subsequently, the patient died of pneumonia and progressive renal failure.
Chronic GVHD, which is associated with severe immune dysfunction and increased frequency of infections, may show numerous Howell-Jolly bodies. Normally, Howell-Jolly bodies are remnants of the erythroblast nucleus that are removed by the spleen. In patients with cGVHD, their appearance is associated with functional asplenia (Kalhs et al. Ann Intern Med. 1988;109:461-464).
Many Blood Work images are provided by the ASH IMAGE BANK, a reference and teaching tool that is continually updated with new atlas images and images of case studies. For more information or to contribute to the Image Bank, visit www.ashimagebank.org.